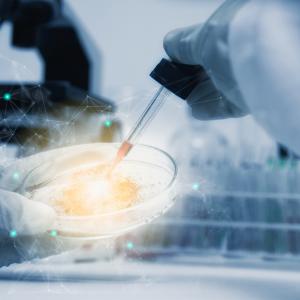

Науката е готова за масово клониране на живи организми
Японски учени от Центъра за еволюционна биология RIKEN в Кобе постигнаха исторически пробив в клонирането на животни. Разработеният от тях метод позволява една наследствена линия да бъде клонирана многократно без негативни отражения върху здравето на „потомствените клонинги” Т.е. децата на клонирани животни да бъдат клонирани, тяхното потомство също да бъде клонирано и т.н. до безкрайност.
От раждането на легендарната овца Доли през 1996 г. до днес клонирането на живи организми е изключително сложен и труден за контролиране процес, който в повечето случаи създаваше болни животни. Дори ако клонингите бяха здрави, то тяхното поколение страдаше от сериозни здравословни проблеми. В резултат, до момента учените не бяха успявали да създадат повече от шест последователни жизнеспособни поколения от клонинги. Тези проблеми се дължат на натрупването на нежелани промени в ДНК, при всяко следващо клониране. На този фон актуалното постижение на японските изследователи е наистина впечатляващо. Започвайки от 2005 г. екипът на д-р Терухико Уакаяма е клонирал една единствена мишка в продължение на 25 поколения, създавайки общо 581 клонинга на оригиналното животно, всичките в отлично здраве. Учените са постигнали този успех чрез усъвършенстването на всяка стъпка от традиционната процедура за клониране SNCT (somatic cell nuclear transfer - ядрен трансфер от соматични клетки).
Един от използваните за това методи е поставянето на генетичния материал в „баня” от ензима трихостатин, който намалява промените в ДНК. Този пробив може да позволи масово производство на клонинги, като на теория един единствен организъм може да доведе до създаването на милиони негови генетични копия. Технологията вероятно ще намери огромен пазар за възпроизвеждането на расови животни, което е сериозна индустрия дори при досегашното развитие на технологиите за клониране. Интересна перспектива е и възможното използване на клонинги за възраждането на някой изчезващ вид. "Тази техника може да бъде много полезна за мащабно производство на елитни животни, за селското стопанство или за опазването на биологични видове”, обобщава д-р Уакаяма.